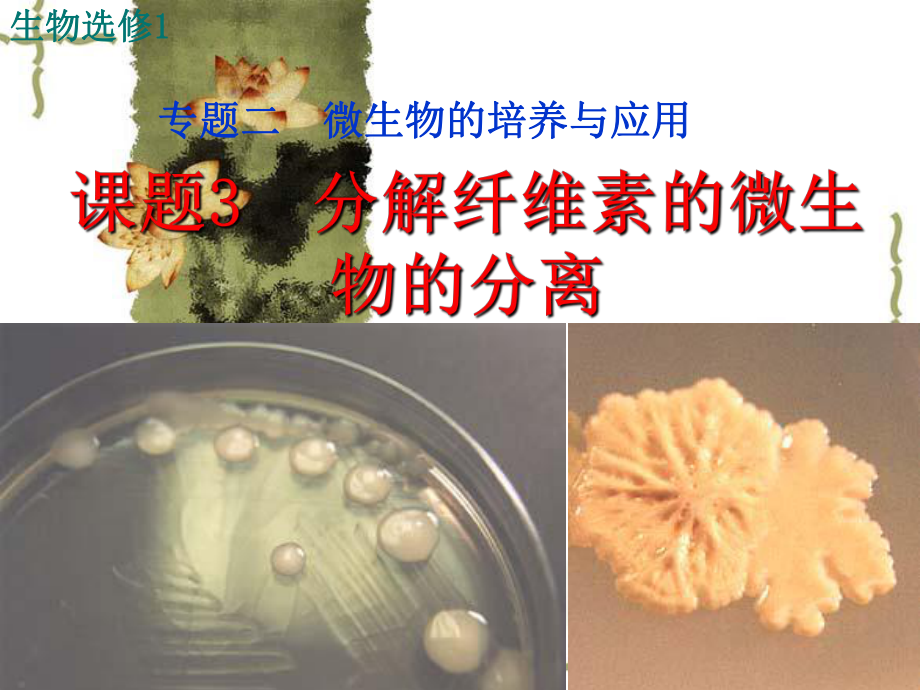
第1页

2.3--分解纤维素的细菌的分离
2021/3/111专题二专题二 微生物的培养与应用微生物的培养与应用生物选修生物选修1 12021/3/112 棉花棉花是自然界中纤维素含量最高的天然产是自然界中纤维素含量最高的天然产物此外,木材、作物秸秆等也富含纤维素此外,木材、作物秸秆等也富含纤维素2021/3/113思考:纤维素是地球上含量最丰富的多糖类物思考:纤维素是地球上含量最丰富的多糖类物质,植物每年产生的纤维素超过质,植物每年产生的纤维素超过7070亿吨,但却亿吨,但却不会在地球上大量的积累,为什么?不会在地球上大量的积累,为什么?2021/3/114纤维二糖纤维二糖C C1 1酶、酶、CxCx酶酶葡萄糖苷酶葡萄糖苷酶葡萄糖葡萄糖纤维素纤维素2021/3/115取二支取二支20mL20mL的试管的试管实验:纤维素酶分解纤维素的实验实验:纤维素酶分解纤维素的实验各加入一张滤纸条各加入一张滤纸条各加入各加入pH4.8pH4.8,物质量为,物质量为0.1mol/L0.1mol/L的醋酸醋酸钠缓冲液的醋酸醋酸钠缓冲液11ml11ml和和10ml10ml甲甲 乙乙在乙试管中加入在乙试管中加入1mL1mL纤维素酶纤维素酶两支试管固定在锥形瓶中,放在两支试管固定在锥形瓶中,放在140r/min140r/min的摇床上振荡的摇床上振荡1h1h结果:乙试管的滤纸条消失结果:乙试管的滤纸条消失 讨论讨论:乙试管的滤纸条为什么会消失?甲试管的作用是:乙试管的滤纸条为什么会消失?甲试管的作用是什么?什么?2021/3/116提示:提示:本实验的自变量是纤维素酶的有无,自变本实验的自变量是纤维素酶的有无,自变量的操纵方法是:在一支试管中添加适量(量的操纵方法是:在一支试管中添加适量(1mL1mL)的纤维素酶溶液,在另一支试管不添加纤维素的纤维素酶溶液,在另一支试管不添加纤维素酶,但需加入等量的缓冲液,不能加入蒸馏水,酶,但需加入等量的缓冲液,不能加入蒸馏水,否则会影响溶液的否则会影响溶液的pHpH。
实验分析:实验分析:P P2727的小实验是如何构成对照的小实验是如何构成对照的?的?2021/3/117 刚果红能与纤维素形成红色复合物刚果红能与纤维素形成红色复合物,而不与,而不与水解后的纤维二糖和葡萄糖发生这种反应水解后的纤维二糖和葡萄糖发生这种反应二)纤维素分解菌的筛选(二)纤维素分解菌的筛选 当我们在含有纤维素的培养基中加入刚果红当我们在含有纤维素的培养基中加入刚果红时,刚果红能与培养基中的纤维素形成红色复时,刚果红能与培养基中的纤维素形成红色复合物当纤维素被纤维素酶分解后,刚果红合物当纤维素被纤维素酶分解后,刚果红-纤纤维素的复合物就无法形成,培养基中就会出现维素的复合物就无法形成,培养基中就会出现以纤维素分解菌为中心的透明圈,这样我们就以纤维素分解菌为中心的透明圈,这样我们就可以通过是否产生透明圈来筛选纤维素分解菌可以通过是否产生透明圈来筛选纤维素分解菌2021/3/1182021/3/119 请你根据实验流程图和提供的三个资料以及请你根据实验流程图和提供的三个资料以及“操作操作提示提示”,在思考有关问题的基础上,设计出一个详细的,在思考有关问题的基础上,设计出一个详细的实验方案。
实验方案土壤取样土壤取样选择培养选择培养梯度稀释梯度稀释 将样品涂布在鉴别纤将样品涂布在鉴别纤 维素分解菌的培养基上维素分解菌的培养基上 筛选产生透筛选产生透 明圈的菌落明圈的菌落2021/3/1110由于生物适应一定的环境,环境对生物有选由于生物适应一定的环境,环境对生物有选择作用,在富含纤维素的环境中,纤维素分解菌择作用,在富含纤维素的环境中,纤维素分解菌的含量相对提高,因此从这种土样中获得目的微的含量相对提高,因此从这种土样中获得目的微生物的几率要高于普通环境生物的几率要高于普通环境2021/3/1111将滤纸埋在土壤中能使纤维素分解菌相对将滤纸埋在土壤中能使纤维素分解菌相对集中,实际上是人工设置纤维素分解菌生存的集中,实际上是人工设置纤维素分解菌生存的适宜环境一般应将滤纸埋于深约适宜环境一般应将滤纸埋于深约10cm10cm左右的左右的土壤中2021/3/1112 2021/3/1113培养基成分分析培养基成分分析培养基组成培养基组成提供主要的营养物质提供主要的营养物质纤维素粉纤维素粉 5g碳源(能源)碳源(能源)NaNO3 1g氮源、无机盐氮源、无机盐KCl 0.5g Na2HPO47H2O 1.2gKH2PO4 0.9g MgSO4 7H2O 0.5g无机盐无机盐酵母膏酵母膏 0.5g生长因子、碳源、氮源生长因子、碳源、氮源水解酵素水解酵素 0.5g氮素、生长因子氮素、生长因子溶解后,蒸馏水定容至溶解后,蒸馏水定容至1000mL水水2021/3/1114提示:自变量为培养基的种类,即普通培养基和选择提示:自变量为培养基的种类,即普通培养基和选择培养基。
可用牛肉膏蛋白胨培养基与之对照培养基可用牛肉膏蛋白胨培养基与之对照,或者将纤或者将纤维素改为葡萄糖维素改为葡萄糖有选择作用,本配方中纤维素作为主要碳源,只有能有选择作用,本配方中纤维素作为主要碳源,只有能分解纤维素的微生物可以大量繁殖分解纤维素的微生物可以大量繁殖2021/3/11152021/3/1116思考:本实验的流程与课题思考:本实验的流程与课题2 2中的实验流程有哪些中的实验流程有哪些异同?异同?本实验流程与课题本实验流程与课题2 2的流程的区别如下课的流程的区别如下课题题2 2是将土样制成的菌悬液直接涂布在以尿素为是将土样制成的菌悬液直接涂布在以尿素为惟一氮源的选择性培养基上,直接分离得到菌惟一氮源的选择性培养基上,直接分离得到菌落本课题通过选择培养,使纤维素分解菌得落本课题通过选择培养,使纤维素分解菌得到增殖后,再将菌液涂布在选择培养基上其到增殖后,再将菌液涂布在选择培养基上其他步骤基本一致他步骤基本一致2021/3/1117P29旁栏思考旁栏思考2021/3/11182021/3/11192021/3/11202021/3/1121P29旁栏思考题旁栏思考题2021/3/1122方法一中方法一中NaCl溶液的作用?溶液的作用?思考:思考:漂洗作用,洗去与纤维素结合不牢的刚果红,漂洗作用,洗去与纤维素结合不牢的刚果红,以免出现的透明圈不够清晰。
用这方法可以判断酶以免出现的透明圈不够清晰用这方法可以判断酶活力的大小,实际上刚果红是结合到培养基的多糖活力的大小,实际上刚果红是结合到培养基的多糖底物,但分解纤维素的细菌可以产生纤维素酶,能底物,但分解纤维素的细菌可以产生纤维素酶,能分解这个多糖底物成为单糖,这样刚果红就不能结分解这个多糖底物成为单糖,这样刚果红就不能结合上去了,氯化钠溶液就可以使结合不牢的刚果红合上去了,氯化钠溶液就可以使结合不牢的刚果红洗去,这样就留下大大小小的透明圈,大的透明圈洗去,这样就留下大大小小的透明圈,大的透明圈当然分解纤维素的能就强!当然分解纤维素的能就强!2021/3/11232021/3/1124 1.1.培养基的制作是否合格以及选择培养基是否筛选培养基的制作是否合格以及选择培养基是否筛选出菌落出菌落 对照的培养基在培养过程中没有菌落生长则说明对照的培养基在培养过程中没有菌落生长则说明培养基制作合格如果观察到产生透明圈的菌落,则培养基制作合格如果观察到产生透明圈的菌落,则说明可能获得了分解纤维素的微生物说明可能获得了分解纤维素的微生物2.2.分离的结果是否一致分离的结果是否一致 由于在土壤中细菌的数量远远高于真菌和放线菌由于在土壤中细菌的数量远远高于真菌和放线菌的数量,因此最容易分离得到的是细菌。
但由于所取的数量,因此最容易分离得到的是细菌但由于所取土样的环境不同,不同同学也可能得到真菌和放线菌土样的环境不同,不同同学也可能得到真菌和放线菌等不同的分离结果等不同的分离结果2021/3/1125 为了确定分离得到的是纤维素分解菌,为了确定分离得到的是纤维素分解菌,还需要进行还需要进行_实验,纤维素酶的实验,纤维素酶的发酵方法有发酵方法有_ _ 发酵和发酵和_ _ 发酵纤维素酶测定方法是对纤维素酶分解滤纸等纤维素酶测定方法是对纤维素酶分解滤纸等纤维素所产生的维素所产生的_ _ 含量进行定量测定含量进行定量测定发酵产纤维素酶发酵产纤维素酶 液体液体 固体固体 2021/3/1126分解分解纤维纤维素的素的微生微生物的物的分离分离纤维素酶纤维素酶种类、作用、催化活力种类、作用、催化活力刚果红染色刚果红染色筛选原理筛选原理实实验验设设计计土壤取样土壤取样选择培养选择培养涂布培养涂布培养纯化培养纯化培养前置染色法前置染色法后置染色法后置染色法富含纤维素土壤富含纤维素土壤增大分解菌含量增大分解菌含量染色鉴别染色鉴别分离出分解菌分离出分解菌2021/3/11271.1.下列关于纤维素酶的说法,错误的是下列关于纤维素酶的说法,错误的是 ()A.A.纤维素酶是一种复合酶,至少包括三种纤维素酶是一种复合酶,至少包括三种B.B.纤维素酶可把纤维素分解成葡萄糖纤维素酶可把纤维素分解成葡萄糖C.C.纤维素酶可用于去掉植物的细胞壁纤维素酶可用于去掉植物的细胞壁D.D.葡萄糖苷酶可把纤维素分解成葡萄糖葡萄糖苷酶可把纤维素分解成葡萄糖D D课堂练习课堂练习2021/3/11282.2.利用刚果红法可以筛选出纤维素分解菌,下列利用刚果红法可以筛选出纤维素分解菌,下列说法错误的是说法错误的是 ()A.A.刚果红能与纤维素形成红色复合物刚果红能与纤维素形成红色复合物 B.B.刚果红能与纤维二糖形成红色复合物刚果红能与纤维二糖形成红色复合物 C.C.刚果红不能与葡萄糖形成红色复合物刚果红不能与葡萄糖形成红色复合物D.D.若培养基上产生了透明圈,则说明已筛若培养基上产生了透明圈,则说明已筛选出了纤维素分解菌选出了纤维素分解菌B B2021/3/1129D 3.3.纤维素分解菌的选择培养基有选择作用,纤维素分解菌的选择培养基有选择作用,原因在于其含有原因在于其含有 ()()A ANaNO3 BNaNO3 BKCl KCl C C酵母膏酵母膏 D D纤维素粉纤维素粉2021/3/1130C 4.4.刚果红染色时,加入刚果红可在刚果红染色时,加入刚果红可在()()制备培养基时制备培养基时 梯度稀释时梯度稀释时 倒平板时倒平板时 涂布时涂布时 培养基上长出菌落时培养基上长出菌落时 A A B B C C D D2021/3/11315分离纤维素分解菌的实验过程中操作有误的是分离纤维素分解菌的实验过程中操作有误的是()A经选择培养后将样品涂布到鉴别纤维素分解菌经选择培养后将样品涂布到鉴别纤维素分解菌的培养基上的培养基上B富集培养这一步可省略,但培养纤维素分解菌富集培养这一步可省略,但培养纤维素分解菌少少C经稀释培养后,用刚果红染色经稀释培养后,用刚果红染色D对照组可用同样量的培养液涂布到不含纤维素对照组可用同样量的培养液涂布到不含纤维素的培养基上的培养基上解析:经选择培养后,再经稀释,才能将样品解析:经选择培养后,再经稀释,才能将样品涂布到鉴别纤维素分解菌的培养基上;富集培养可涂布到鉴别纤维素分解菌的培养基上;富集培养可省略;经稀释培养后,用刚果红染色;设置对照能省略;经稀释培养后,用刚果红染色;设置对照能证明经富集培养的确得到了欲分离的微生物证明经富集培养的确得到了欲分离的微生物.A A2021/3/1132v6下图为分离并统计分解纤维素的微生物的下图为分离并统计分解纤维素的微生物的实验流程,据此回答有关问题:实验流程,据此回答有关问题:v(1)(1)要从富含纤维素的环境中分离纤维素分解要从富含纤维素的环境中分离纤维素分解菌,从高温热泉中寻找耐热菌,这说明菌,从高温热泉中寻找耐热菌,这说明_。
v根据目的菌株对生存环境的要求,到相应根据目的菌株对生存环境的要求,到相应的环境中去寻找的环境中去寻找2021/3/1133v(2)(2)某同学根据需要,配制了纤维素分解菌的培某同学根据需要,配制了纤维素分解菌的培养基如下,整个实验过程严格执行无菌操作养基如下,整个实验过程严格执行无菌操作v如果将其中的纤维素粉换成如果将其中的纤维素粉换成_,菌落数,菌落数_,即可说明选择,即可说明选择培养基的作用培养基的作用纤维素粉纤维素粉NaNO3Na2HPO47H2OKH2PO45 g1 g1.2 g0.9 gMgSO47H2OKCl酵母膏、水解酪素0.5 g0.5 g适量葡萄糖葡萄糖明显多于选择培养基上的菌落数明显多于选择培养基上的菌落数2021/3/1134v(3)(3)接种微生物最常用的是平板划线法和稀释接种微生物最常用的是平板划线法和稀释涂布平板法,本实验宜采用涂布平板法,本实验宜采用_ _ 法,法,v原因是原因是_稀释涂布平板稀释涂布平板v平板划线法难以根据稀释体积计算每克样平板划线法难以根据稀释体积计算每克样品中的细菌数品中的细菌数2021/3/1135v【解析解析】(1)(1)因为纤维素分解菌与耐热菌有不因为纤维素分解菌与耐热菌有不同的生活习性,生活在不同的环境中,故要根据同的生活习性,生活在不同的环境中,故要根据目的菌株对生存环境的要求,到相应的环境中去目的菌株对生存环境的要求,到相应的环境中去寻找。
寻找2)(2)因为葡萄糖是纤维素水解的、能被微因为葡萄糖是纤维素水解的、能被微生物直接利用的有机小分子,所以如果将其中的生物直接利用的有机小分子,所以如果将其中的纤维素粉换成葡萄糖,纤维素分解菌及其他细菌纤维素粉换成葡萄糖,纤维素分解菌及其他细菌会生长繁殖得更快,故菌落数明显多于选择培养会生长繁殖得更快,故菌落数明显多于选择培养基3)(3)因为稀释涂布平板法要将菌液进行一系因为稀释涂布平板法要将菌液进行一系列的梯度稀释,故该法可根据稀释体积计算每克列的梯度稀释,故该法可根据稀释体积计算每克样品中的细菌数,而平板划线法则不能这样,所样品中的细菌数,而平板划线法则不能这样,所以本实验宜采用稀释涂布平板法以本实验宜采用稀释涂布平板法2021/3/1136v7.7.有些微生物能合成纤维素酶,通过对这些微生物的研有些微生物能合成纤维素酶,通过对这些微生物的研究和应用,使人们能够利用秸秆等废弃物生产酒精,用究和应用,使人们能够利用秸秆等废弃物生产酒精,用纤维素酶处理服装面料等研究人员用化合物纤维素酶处理服装面料等研究人员用化合物A A、硝酸、硝酸盐、磷酸盐以及微量元素配制的培养基,成功地筛选到盐、磷酸盐以及微量元素配制的培养基,成功地筛选到能产生纤维素酶的微生物。
分析回答问题:能产生纤维素酶的微生物分析回答问题:v(1)(1)培养基中加入的化合物培养基中加入的化合物A A是是_,为微生物的生,为微生物的生长提供长提供_,这种培养基从用途上进行分类,应属,这种培养基从用途上进行分类,应属于于_培养基v(2)(2)为了筛选出能产生纤维素酶的微生物,还应向培养为了筛选出能产生纤维素酶的微生物,还应向培养基中加入基中加入_v(3)(3)若用平板划线法获得纯净的菌株,请回答:若用平板划线法获得纯净的菌株,请回答:v在接种时,为什么在操作的第一步以及每次划线之前在接种时,为什么在操作的第一步以及每次划线之前都要灼烧接种环?都要灼烧接种环?v在划线操作结束时,仍然需要灼烧接种环吗?为什么?在划线操作结束时,仍然需要灼烧接种环吗?为什么?v除此之外,还可用除此之外,还可用_方法来获得纯净的菌株方法来获得纯净的菌株2021/3/1137v【解析解析】若筛选到能利用纤维素若筛选到能利用纤维素(可产生纤可产生纤维素酶维素酶)的微生物,培养基中加入的化合物的微生物,培养基中加入的化合物A A,应为纤维素制备只以纤维素作碳源的选择应为纤维素制备只以纤维素作碳源的选择培养基,能在该培养基中生长的微生物应为培养基,能在该培养基中生长的微生物应为可产生纤维素酶的微生物,此即目标微生物。
可产生纤维素酶的微生物,此即目标微生物2021/3/1138v【答案答案】v(1)(1)纤维素碳源选择纤维素碳源选择v(2)(2)刚果红刚果红v(3)(3)第一步灼烧接种环是防止接种环上有其第一步灼烧接种环是防止接种环上有其他微生物而污染培养基;每次划线前灼烧接他微生物而污染培养基;每次划线前灼烧接种环是为了杀死上次接种时留下的菌种,使种环是为了杀死上次接种时留下的菌种,使下一次划线时接种环上的菌种直接来自上次下一次划线时接种环上的菌种直接来自上次划线的末端,以便通过多次划线后,得到单划线的末端,以便通过多次划线后,得到单个的菌落个的菌落v划线结束后仍要灼烧接种环,以免菌种对划线结束后仍要灼烧接种环,以免菌种对环境造成污染环境造成污染v稀释涂布平板稀释涂布平板2021/3/1139v8.(2004天津理综)天津理综)淀粉酶可以通过微生物发酵生淀粉酶可以通过微生物发酵生产,为了提高酶的产最,请你设计一个实验,利用产,为了提高酶的产最,请你设计一个实验,利用诱变育种方法,获得产生淀粉酶较多的菌株诱变育种方法,获得产生淀粉酶较多的菌株v写出主要实验步骤写出主要实验步骤v根据诱发突变率低和诱发突变不定向性的特点预根据诱发突变率低和诱发突变不定向性的特点预期实验结果。
期实验结果v提示:生产菌株在含有淀粉的固体培养基上,随其提示:生产菌株在含有淀粉的固体培养基上,随其生长可释放淀粉酶分解培养基中的淀粉,在菌落周生长可释放淀粉酶分解培养基中的淀粉,在菌落周围形成透明圈围形成透明圈解析:这是一道以诱变育种、选择培养和鉴别培解析:这是一道以诱变育种、选择培养和鉴别培养等知识为载体的实验设计题,综合性强,难度较养等知识为载体的实验设计题,综合性强,难度较大既要求学生掌握实验原理,也要求学生具备较大既要求学生掌握实验原理,也要求学生具备较强的实验设计的能力及对实验结果的预测和分析能强的实验设计的能力及对实验结果的预测和分析能力2021/3/1140v答案:答案:v主要实验步骤:主要实验步骤:v第一步:将培养好的生产菌株分两组一组用一定剂第一步:将培养好的生产菌株分两组一组用一定剂量的诱变剂处理,另一组不处理做对照量的诱变剂处理,另一组不处理做对照v第二步:制备含淀粉的固体培养基第二步:制备含淀粉的固体培养基v第三步:把诱变组的大量菌株接种于多个含淀粉的固第三步:把诱变组的大量菌株接种于多个含淀粉的固体培养基上,同时接种对照组,相同条件下培养体培养基上,同时接种对照组,相同条件下培养。
v第四步:比较两组菌株菌落周围透明圈的大小,选出第四步:比较两组菌株菌落周围透明圈的大小,选出透明圈变大的菌株透明圈变大的菌株v预期实验结果:预期实验结果:va a由于诱发突变率低,诱变组中绝大多数菌落周围的由于诱发突变率低,诱变组中绝大多数菌落周围的透明圈大小与对照组相同透明圈大小与对照组相同vb b由于诱发突变不定向性,诱变组中极少数菌落周围由于诱发突变不定向性,诱变组中极少数菌落周围的透明圈与对照组相比变大或变小的透明圈与对照组相比变大或变小2021/3/1141提示:提示:土壤取样土壤取样选择培养(此步是否需要,应根据选择培养(此步是否需要,应根据样品中目的菌株数量的多少来确定)样品中目的菌株数量的多少来确定)梯度稀梯度稀释释将菌悬液涂布到有特定选择作用的培养基将菌悬液涂布到有特定选择作用的培养基上上挑选单菌落挑选单菌落发酵培养发酵培养课后练习课后练习2:。




